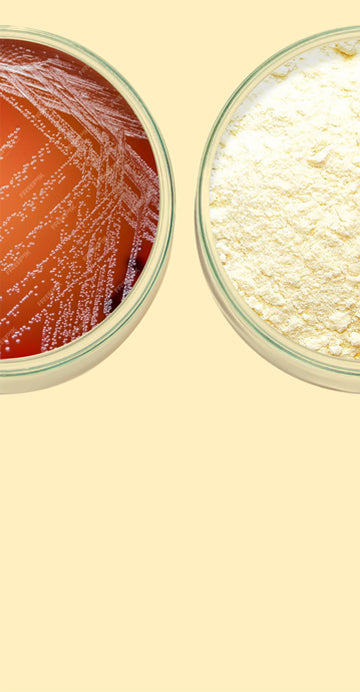

Your Cart
The Gut Superblend - Daily Gut Health Drink (Prebiotic + Probiotic + Postbiotic+ Phytobiotic)
A smooth, gut-friendly drink powder that mixes in seconds.
Digestive health support: Supports healthy digestion and regularity.*
Energy & focus: Helps maintain steady energy and mental clarity.*
Gut microbiome balance: Supports a balanced gut microbiome.*
Immune support: Supports healthy immune function.*
Metabolic health: Helps support glucose metabolism and cholesterol levels already within the normal range.*
SFG Biome’s Gut Superblend is a daily gut-health drink that combines prebiotics, probiotics, postbiotics and polyphenol-rich botanicals (phytobiotics) to support healthy digestion, microbiome balance and everyday vitality. It nourishes the gut lining and the gut-brain axis to support regularity, help you feel steady energy and mental clarity - with no unnecessary fillers and a smooth taste that mixes in seconds.*
Resistant Potato Starch (Solnul®), Partially Hydrolyzed Guar Gum (Sunfiber®), Barley Beta Glucan (Barley Balance®), Oat Beta Glucan (OatWell®), Locust Bean Gum (Naltive®), Saccharomyces boulardii (Lynside® PRO SCB), Lactobacillus rhamnosus GG (LifeinU®), Lactobacillus paracasei LPC-37®, Lactobacillus acidophilus NCFM®, Bifidobacterium lactis HN019®, Bacillus coagulans (LactoSpore®), Lactococcus lactis Strain Plasma (IMMUSE™), Green Kiwifruit (Actazin®), Gold Kiwifruit (Livaux®), Pomegranate (Pomma+®), European Black Elderberry (ElderCraft®), Lychee (Oligonol®), Turmeric Rhizome Extract
Other Ingredients: Rice Fiber, Monk Fruit Extract, Natural Flavor.
Start slow. Mix 1 scoop daily into 8-10 fl oz of cool or room-temperature liquid for the first week. From week 2, increase to up to 2 scoops daily as tolerated. Stir or shake well and consume within 10 minutes. Take with or without food - consistency matters most

90 Days Money Back Guarantee

No Refrigeration Needed

Free Shipping on All Orders
Real Results You Can Feel
Expertly formulated with prebiotics, probiotics, postbiotics, and polyphenol-rich
botanicals. Benefits supported by research on key ingredients.*
Digestive Comfort*
Supports digestive comfort and helps maintain regularity.
Digestive Comfort*
Supports digestive comfort and helps maintain regularity.
The Science Behind It
Soluble prebiotic fibers and beta-glucans support normal transit time and stool form, promoting comfortable digestion.
Key Ingredients
• Guar Gum Fiber (Sunfiber®)
• Barley Beta Glucan (Barley Balance®)
• Oat Beta Glucan (OatWell®)
Bowel Regularity*
Supports healthy, regular bowel movements.
Bowel Regularity*
Supports healthy, regular bowel movements.
The Science Behind It
Prebiotic fibers and kiwifruit powder help maintain proper motility; Targeted probiotics support gut function.
Key Ingredients
• Green Kiwi Fruit Powder (Actazin®)
• Guar Gum Fiber (Sunfiber®)
• Bifidobacterium lactis HN019®
• Bacillus coagulans (LactoSpore®)
• Lactobacillus acidophilus NCFM®
Gut Microbiome Balance*
Helps nourish beneficial bacteria and support a balanced gut microbiome.
Gut Microbiome Balance*
Helps nourish beneficial bacteria and support a balanced gut microbiome.
The Science Behind It
Prebiotics feed friendly microbes; Resistant starch and specific strains help beneficial species thrive.
Key Ingredients
• Lactobacillus rhamnosus GG (LifeinU®)
• Saccharomyces boulardii (Lynside® PRO SCB)
• Gold Kiwifruit (Livaux®)
• Resistant Potato Starch (Solnul®)
• Guar Gum Fiber (Sunfiber®)
Energy & Focus*
Helps maintain steady energy and mental clarity throughout the day.
Energy & Focus*
Helps maintain steady energy and mental clarity throughout the day.
The Science Behind It
Fibers and beta-glucans support efficient carbohydrate metabolism; Select strains support the gut–brain connection related to clarity.
Key Ingredients
• Lactobacillus rhamnosus GG (LifeinU®)
• Guar Gum Fiber (Sunfiber®)
• Barley Beta-Glucan (Barley Balance®)
• Oat Beta-Glucan (OatWell®)
Focus & Clarity *
Supports the gut-brain axis for mental clarity and a balanced mood.
Focus & Clarity *
Supports the gut-brain axis for mental clarity and a balanced mood.
The Science Behind It
The gut interacts with neurotransmitters (e.g., serotonin). Fibers, resistant starch, and select strains help maintain healthy gut-brain signaling.
Key Ingredients
• Resistant Potato Starch (Solnul®)
• Guar Gum Fiber (Sunfiber®)
• Lactobacillus paracasei LPC-37®
• Bacillus coagulans (LactoSpore®)
Metabolic Health*
Supports healthy glucose metabolism and cholesterol levels already within the normal range.
Metabolic Health*
Supports healthy glucose metabolism and cholesterol levels already within the normal range.
The Science Behind It
Beta-glucans and select botanicals help support lipid and glucose parameters as part of a healthy lifestyle.
Key Ingredients
• Guar Gum Fiber (Sunfiber®)
• Barley Beta-Glucan (Barley Balance®)
• Oat Beta-Glucan (OatWell®)
• Lychee Extract (Oligonol®)
Immune Support*
Supports a healthy immune response.
Immune Support*
Supports a healthy immune response.
The Science Behind It
Postbiotic LC-Plasma, targeted probiotics, and plant antioxidants support immune cell communication and barrier function.
Key Ingredients
• Lactococcus lactis Strain Plasma (IMMUSE™)
• Bifidobacterium lactis HN019™
• Lactobacillus acidophilus NCFM®
• European Black Elderberry (ElderCraft®)
• Green Kiwifruit (Actazin®)
• Gold Kiwifruit (Livaux®)
• Turmeric Rhizome Extract
Circulatory Health*
Supports circulatory health and lipid parameters already within the normal range.
Circulatory Health*
Supports circulatory health and lipid parameters already within the normal range.
The Science Behind It
Beta-glucans and polyphenols support endothelial function and healthy lipid profiles.
Key Ingredients
• Pomegranate Extract (Pomma+®)
• Turmeric Curcumin
• Barley Beta-Glucan (Barley Balance®)
• Oat Beta-Glucan (OatWell®)
One Simple Serving. Daily Gut Support.
A smooth gut-health drink that mixes in seconds
Supports digestion, microbiome balance, and steady energy - without complicated routines. Powered by prebiotics, probiotics, postbiotics, and polyphenol-rich botanicals (phytobiotics).*
Free from what you don’t need:





Step 1 - Dose
Week 1: 1 scoop daily.
Week 2+: 2 scoops daily if desired and well-tolerated.

Step 2 - Mix
Per scoop: 8–10 oz cold water (or a smoothie). Shake 10–15 seconds until smooth.
Using 2 scoops? Use 12–16 oz.
Step 3 - When
Enjoy once daily - with breakfast, mid-afternoon, or with dinner. New to added fiber? Start with morning use, then choose the time you prefer.

Step 4 - Pro tips
Avoid hot or carbonated liquids. Great with citrus, berries, or over ice. Mixes in seconds; no refrigeration needed.
Prebiotic + Probiotic + Postbiotic + Phytobiotics - in One Gut-Health Drink
Compare our multi-benefit blend with typical single-category products.
Formulations vary by brand; This table shows categories, not disease outcomes.
Why it matters
What this means for you: Broader support for digestion, microbiome balance, immune and metabolic health - in one daily serving.*







